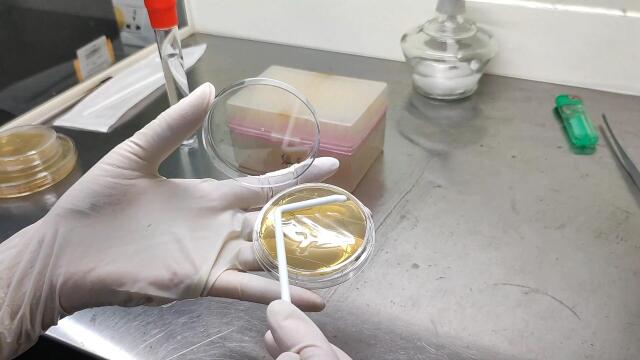
接触皿涂布接种操作介绍

涂布法

涂布实验图片
图片尺寸793x680
涂布法接种细菌
图片尺寸532x345
涂布平板法(spread platemethod)
图片尺寸565x223
稀释倒平板和涂布法
图片尺寸342x200
涂布著膜原理 涂布轮 油膜 内层板 涂布量
图片尺寸1080x810
稀释涂布(平板)法
图片尺寸686x420
1ml悬液,均 匀涂布于初筛培养基平板上,于30℃培养24-48h.
图片尺寸1080x810
涂布平板法
图片尺寸541x364
平板涂布法 15稀释平板测数法 (混融法和涂布法
图片尺寸1080x810
三种常见的精密涂布方式对比
图片尺寸599x279
上述方法称为稀释涂布平板法b.3号试管中的
图片尺寸420x200
(1)涂布平板法的实质是什么?
图片尺寸645x379
五,稀释涂布平板法
图片尺寸947x462
67手把手教你倒平板划平板涂布操作
图片尺寸770x403
接触皿涂布接种操作介绍
图片尺寸640x360
三种常见的精密涂布方式对比
图片尺寸603x270
梯度稀释过程 倾注 涂布
图片尺寸1080x810
图4-39 喷枪涂布法示意图
图片尺寸186x208
07.平板涂布操作
图片尺寸1440x900
涂布方法介绍
图片尺寸802x340